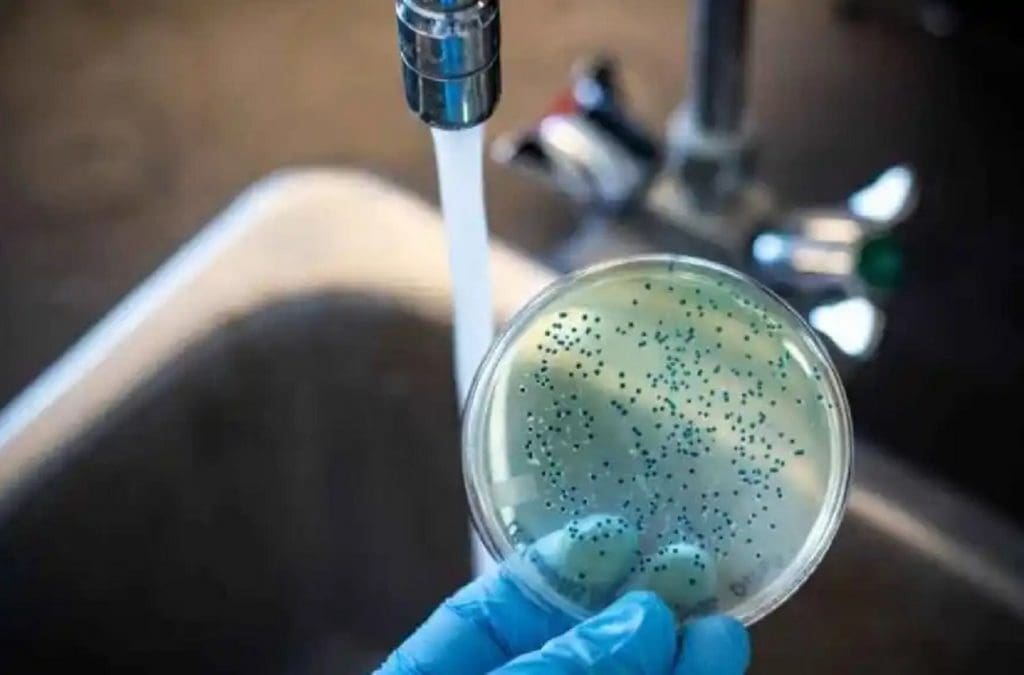
JLB COLERA

“Es importante cuidarnos para evitar la irrupción del cólera en Aguascalientes”, manifestó el secretario de Salud, Rubén Galaviz Tristán, luego de revelar que en algunas zonas del país ya comenzaron a brotar los casos de esa enfermedad bacteriana.
Mencionó que la principal fuente del cólera resultan ser los alimentos y el agua contaminada, por lo que es muy importante reforzar la higiene en la preparación, manejo y consumo de ciertos productos, como es el caso de los mariscos.
El Estado se mantiene hasta ahora libre del cólera, pero eso no significa que no pueda aparecer la enfermedad, sobre todo si se toma en cuenta que varios estados ya reportan casos, lo que hace que aparezcan los riesgos, advirtió el titular del Sistema Estatal de Salud.
RIESGO LATENTE DE CÓLERA
El doctor Galaviz dijo que el cólera ya tiene presencia y está haciendo de las suya con la salud de la población en algunos estados del país, entre ellos Veracruz, Entidad del sureste del país de donde llega a Aguascalientes producto del mar, ante lo cual se recomienda que ese tipo de alimentos sean bien lavados, cocidos o fritos, para matar las bacterias y reducir los riesgos a la salud.
“En Aguascalientes no tenemos aún casos de cólera y ni queremos tenerlos, por eso es importante cuidarnos dándole un manejo totalmente higiénico a los alimentos”, subrayó.
“El cólera ya está en México; hay algunos estados, entre ellos Veracruz, de donde vienen ostiones y productos que comemos crudos y que son una fuente importante para contraer la enfermedad provocada por las bacterias de los alimentos”, mencionó el titular del ISSEA.
SE EXPANDE LA ENFERMEDAD
El cólera se está extendiendo al país, teniendo actualmente presencia en varios puntos del territorio nacional, sin que sea el caso de Aguascalientes donde se ha mantenido hasta el momento libre de esa enfermedad que se contrae por consumir alimentos o beber agua contaminada por la materia fecal de una persona infectada.
Regulación Sanitaria es el área encargada de monitorear el agua y de realizar acciones preventivas en los establecimientos comerciales con venta de productos del mar, sin que hasta el momento se haya detectado la presencia de la bacteria y tampoco reportado casos sospechosos de esa enfermedad bacteriana.